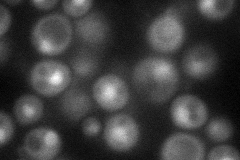
YPR107C
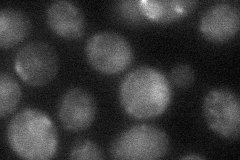
YPR107C
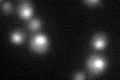
YPR107C
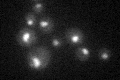
YPR107C

View description
Essential RNA-binding component of cleavage and polyadenylation factor, contains five zinc fingers; required for pre-mRNA 3'-end processing and polyadenylation
Localization:
Intensity:
Fold change:
Significance:
-
C’ GFP library in SD

nucleus25.77 -
N' NOP1pr-GFP in SD
cytosol,nucleus62.6117 -
N' TEF2pr-mCherry in SD

cytosol,nucleus11.5591 -
N' NATIVEpr-GFP in SD

nucleus35.18 -
N' TEF2pr-VC and Cyto-VN in SD
nucleus29.4945 -
C’ GFP library in SD+DTT
nucleus31.81.23No -
C’ GFP library in SD+H2O2

nucleus24.950.96No -
C’ GFP library in Starvation Media
nucleus27.581.07No -
C’ GFP library on the background of Pup2-DaMP

nucleus -
C’ GFP library on the background of CCT mutant

nucleus23.78280.922552No
